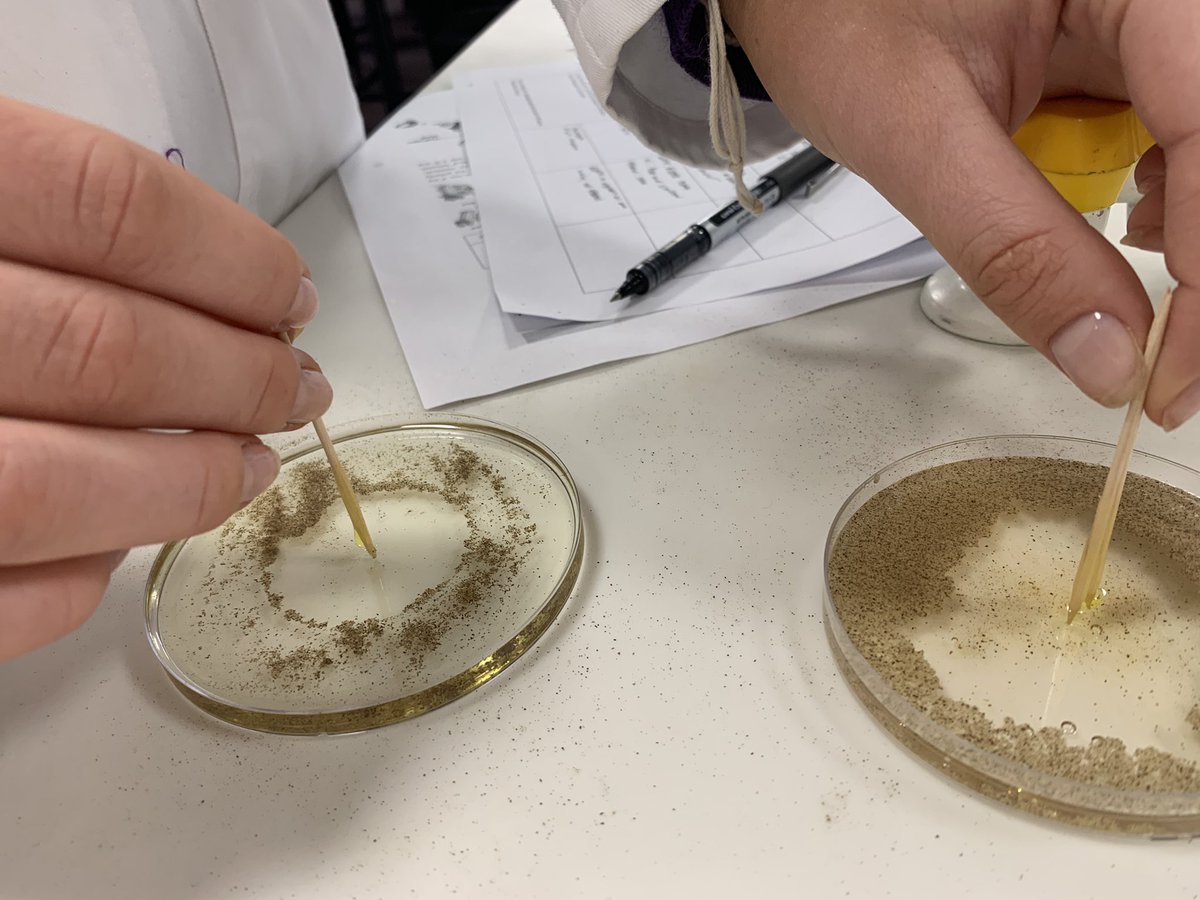
BeckRSaunders's tweet image. #IB #Biology #Topic2 #PropertiesOfWater  Oil v water v ethanol

#topic2 search results
Favorite part of teaching science playing around with labs for my class … next lab #IB #Biology #Topic2 #CellularRespiration

#ibdp #design #topic2 sustainability and the circular economy telegraph.co.uk/connect/better…
Love using visuals like this to help my students break down the key points #EnergySystems #Topic2 #StudySkills #LCPE
The Gaa Club pre season is getting underway for most of the energy system, which is the most valuable asset, a simple breakdown of the energy used

#Discussion #Topic2 #ALLareWelcome #LetsTalkAboutit So you’re in a relationship and someone else is, too; but the two of you are attracted to one another. There’s nothing wrong in either relationship whatsoever. But you all flirt, and possibly text.... Thoughts...?
Is your classroom academically safe? Climate matters! If not use the techniques below to help! Thank you @cultofpedagogy. @SCASCD #climatematters #topic2 #emergED2lead

Linking students learning for Topic 2 (and small section of Topic 3) by focusing on Katie McCabe and completing Team Games Tournament for Sport Psychology and Diet & Nutrition #LCPE #edutwitter

A nice #LCPE article that could be linked into Topic 2 ‘Recovery Strategies’ if paired with a level 5/6 action verb from Blooms Taxonomy to create a class discussion on pro’s & cons 🙌👏
Flipped classroom! 👩🏻🏫👨🏼🏫 5th year LCPE students carried out an investigation into the benefits and side effects of various dietary supplements in relation to performance and then taught one another! #LCPE #investigation #Topic2 #




#RnDmonth #rnd #Topic2 The R&D: Hypotheses are for Scientists not for Businesses... more info here: hubs.ly/H0lb_l90
Brendan Howlin: The rise of the far-right across Europe risks destroying the European Project (via @thejournal_ie) #Topic2 jrnl.ie/6242642
Perfect for #IB #Biology #Topic2 #CarbohydratesAndLipids #BMI
“BMI does not come from science or medicine.” The body mass index measure was never meant as a health diagnostic tool, critics say. nbcnews.to/3MedJjz
nbcnews.com
How an overreliance on BMI can stand between patients and treatment
BMI is tied to a measure of obesity invented almost 200 years ago. Critics say it was never meant as a diagnostic health tool.
#learningseries108 #topic2 Kub sell karna chaiye aur Kub nahi. Candle body mein hi volumes hote hai.

Meet the experts behind #Topic2 of the #EUPVSEC2025! Topic 2 focuses on #ThinFilmPV and emerging PV concepts and innovations beyond silicon. A big thank you to our #ScientificCommittee —your expertise is shaping the #SolarInnovation! 🔗eupvsec.org/index.php/home… #EUPVSEC

Flipped classroom! 👩🏻🏫👨🏼🏫 5th year LCPE students carried out an investigation into the benefits and side effects of various dietary supplements in relation to performance and then taught one another! #LCPE #investigation #Topic2 #




5th year LCPE students are currently learning about the importance of macronutrients in the diet. #Topic2 #LCPE #Investigation


Topic Preview: Thin-Films and New Concepts #Topic2 explores advanced PV tech beyond silicon, with #ThinFilms, tandem solar cells, novel materials, and next-gen renewable energy solutions. Learn more: eupvsec.org/index.php/conf… #EUPVSEC #EUPVSEC2025 #SolarInnovation #Photovoltaics

Thanks for giving your thoughts. May I ask your thoughts on this equally relevant topic. #Topic2 #healthxph

#Learning #Topic2 #PERatio The P/E ratio, or Price-to-Earnings ratio, is a financial metric used to evaluate a company's current share price relative to its earnings per share (EPS).
7/🌟 As we celebrate the core values and journey of bloXmove, let's embark on this continued voyage with enthusiasm and determination. Together, let's shape a future where mobility is sustainable, accessible, and empowering for all! @bloXmove #BloxmoveThreadContest #topic2
Inclusivity is woven into the fabric of our brand. We believe that transportation should be for everyone, regardless of background or circumstance. That's why we strive to make our solutions accessible, affordable, and equitable for all. @bloXmove #BloxmoveThreadContest #topic2
Meet the faces behind the programme creation of #EUPVSEC2024's #Topic2 and its sub-topics! 🌞 bit.ly/3HWOhgV We thank all topic chairs, topic organisers and paper reviewers for your efforts, which are instrumental in shaping the #EUPVSECprogramme! #ScientificCommittee

Exploring the 'motherhood' gap or gender pay gap with students? Direct them to this research 👇🏻 #Topic2 #GenderEquality #Lynch #Walby
Swipe to learn more ➡ ️ Using a trove of data from 134 countries to measure the effect for 95% of the world’s population, researchers have developed a novel approach to calculate the effect parenthood has on mother’s careers. Explore their findings: econ.st/4bCWVij
Love using visuals like this to help my students break down the key points #EnergySystems #Topic2 #StudySkills #LCPE
The Gaa Club pre season is getting underway for most of the energy system, which is the most valuable asset, a simple breakdown of the energy used

Get to know the topics of the #EUPVSEC2024! #Topic2 is divided into 5 subtopics covering various PV materials beyond silicon, including #thinfilms—whether currently used or in the concept or demonstration phase. bit.ly/3TpJLyN #EUPVSEC #Photovoltaics #Research #Abstracts

Brendan Howlin: The rise of the far-right across Europe risks destroying the European Project (via @thejournal_ie) #Topic2 jrnl.ie/6242642
Do not underestimate the amazing work done by @sophiaroediger and all the @bloxmove team until this day.... Time is come to go further 😀 @bloXmove #BloxmoveThreadContest #topic2
@bloXmove #BloxmoveThreadContest #topic2 🌟 Journey of Excellence! 🚀 Bloxmove's core values have paved the way to where we stand today. Let's shine a light on the path:
Math was amazing today! Counting back to subtract was a big hit today! All of the Ss finished before our allotted time! Woohoo! #envision2.0 #Topic2 #subtractionrocks #thedaybeforefieldtripenergy @WAPrimaryAP @HardimonLaquita
Inspecting the universality of DNA structure: comparing results extracted from different plants #ibbio #topic2 @monamajzoub @Hhhsinfo




Favorite part of teaching science playing around with labs for my class … next lab #IB #Biology #Topic2 #CellularRespiration

Concept mapping biomolecules is fun when you can write on the lab benches! #IBbio #topic2 #yorkscience #yorklearns



First question in five minutes!! We'll use #topic1 #topic2 etc. ...you do the same : ) @npquarterly #philchat

RHS junior #IBbio modeling the primary, secondary, tertiary and quarternary structures of proteins. #Topic2.4



#pwgenergy5b #Topic2 Tinkerbell had a lot of potential energy while we were taking this photo because...

IB1 students measure their #BMI values and check that they lie in the normal range then realize the link between lipid consumption and the risk of cardiovascular diseases #IBbio #topic2 @monamajzoub @Hhhsinfo


Is tail fat as healthy as our grandparents think they are? What is the healthiest source of fat out there? IB1's topic of discussion today using @MicrosoftTeams breakout rooms and @wakelet #ibbio #topic2 @Hhhsinfo


Modeling the inter and intramolecular protein interactions using colours, laughs and creativity #ibbio #topic2 @monamajzoub @Hhhsinfo



It's been a long journey for #bloxmove. I remember the day in october 2021, when we launched the token and everyone was very excited to be part of the story. 🧶1/6 @bloXmove #BloxmoveThreadContest #topic2

Meet the experts behind #Topic2 of the #EUPVSEC2025! Topic 2 focuses on #ThinFilmPV and emerging PV concepts and innovations beyond silicon. A big thank you to our #ScientificCommittee —your expertise is shaping the #SolarInnovation! 🔗eupvsec.org/index.php/home… #EUPVSEC

Get to know the topics of the #EUPVSEC2024! #Topic2 is divided into 5 subtopics covering various PV materials beyond silicon, including #thinfilms—whether currently used or in the concept or demonstration phase. bit.ly/3TpJLyN #EUPVSEC #Photovoltaics #Research #Abstracts

Collecting mass and height values to calculate and analyse the Body Mass Index #ibbio #topic2 @monamajzoub @Hhhsinfo



Something went wrong.
Something went wrong.
United States Trends
- 1. Rory N/A
- 2. Swalwell N/A
- 3. Wicks N/A
- 4. AJ Brown N/A
- 5. #OlandriaxBarbie N/A
- 6. TADC N/A
- 7. #TheMasters N/A
- 8. Brandon Marsh N/A
- 9. Mbappe N/A
- 10. #Go_Big_With_SevEN N/A
- 11. Graham N/A
- 12. Mark Lynch N/A
- 13. Shota N/A
- 14. #Boycott_BELIFT_Financially N/A
- 15. Moon Knight N/A
- 16. #Ochella N/A
- 17. BINI PPOP PRIDE N/A
- 18. La ONU N/A
- 19. Girona N/A
- 20. Oreos N/A